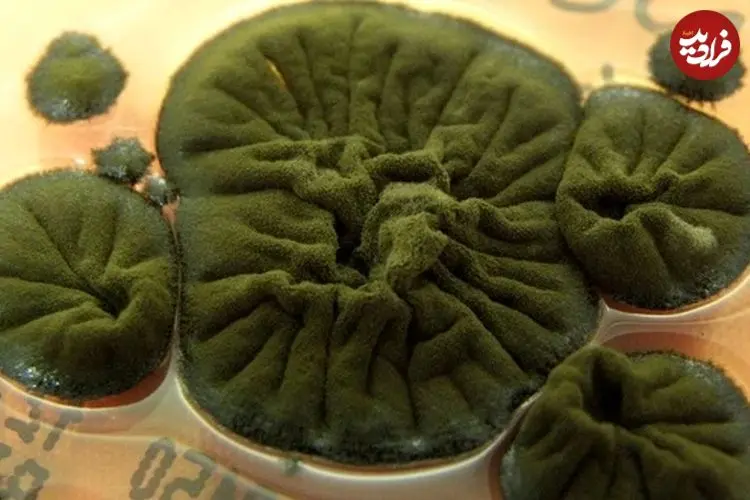
راز عجیب قارچ چرنوبیل چیست و چگونه با محیط سازگار شده‌اند؟

انسانهای منقرضشده چگونه حرف میزدند؟

تحقیقات نشان میدهد نئاندرتالها میتوانستند صحبت کنند، اما احتمالاً توان درک یا استفاده از استعارهها (مقایسه دو چیز مختلف با هم) را نداشتند.
فرادید| معماهای مربوط به یک گونۀ منقرضشده از انسان یعنی نئاندرتالها (Homo neanderthalensis) مدتهاست که محققان و عموم مردم را مجذوب خود کرده است. آنها در بحثهای مربوط به ماهیت جنس انسانی (طبقهبندی بیولوژیکی گستردهای که انسانها و بستگانشان در آن قرار میگیرند) همچنان اهمیت ویژهای دارند. شناخت نئاندرتالها به ویژه از این جهت اهمیت دارد که میتواند به ما در درک بیهمتا بودن یا نبودن گونۀ خودمان یعنی هومو ساپینس کمک کند.
به گزارش فرادید، ما احتمالا در حدود ۶۰۰ هزار سال پیش با نئاندرتالها یک جد مشترک داشتیم اما آنها در اروپا تکامل یافتند و ما در آفریقا. نئاندرتالها حدود ۴۰ هزار سال پیش منقرض شدند در حالیکه ما جهان را پرجمعیت کردیم و به شکوفایی خود همچنان ادامه میدهیم. اینکه آیا این نتیجه متفاوت، بخاطر تفاوت در نوع «زبان و تفکر» بوده است یا خیر، مدتها موضوع بحث بوده است.
اما شواهد تازه به تفاوتهای کلیدی در مغز گونههای ما و نئاندرتالها اشاره میکنند که به انسانهای مدرن اجازه میدهد ایدههای انتزاعی و پیچیده را از طریق استعاره بیان کنند (توانایی مقایسه دو چیز نامرتبط). برای وقوع این اتفاق، گونه ما از لحاظ معماری مغز از نئاندرتالها فاصله گرفت.
برخی کارشناسان در شواهد اسکلتی و باستانشناسی، تفاوتهای عمیقی را مشاهده میکنند، برخی معتقدند هیچ تفاوتی وجود نداشته و برخی حد وسط را گرفتهاند.
هنگام تلاش برای استنتاج چنین نتایج ناملموسی از بقایای مادی مانند استخوانها و دستسازهها، اختلاف نظر عجیب نیست. اما خوشبختانه اکتشافات تازه در باستانشناسی و سایر رشتهها، چندین قطعه جدید را به این معمای زبانی افزوده و تصویری قابلقبول از ذهن نئاندرتالها نمایان شده است.

شواهد فزاینده نشان میدهد تفاوتهای کلیدی بین انسان مدرن و نئاندرتال در استفاده از زبان وجود دارد
شواهد کالبدشناختی جدید نشان میدهد نئاندرتالها مجاری صوتی و مسیرهای شنوایی داشتند که تفاوت قابلتوجهی با مسیرهای شنوایی ما نداشته، یعنی از منظر آناتومیکی، آنها به اندازه ما در برقراری ارتباط از طریق گفتار توانایی داشتند. همچنین کشف ژنهای نئاندرتال در گونههای خودمان نشاندهنده اپیزودهای متعدد آمیختگی و ارتباطات بین گونهای مؤثر و روابط اجتماعی است.
کشف نیزههای چوبی نئاندرتال و استفاده از صمغ به عنوان چسب برای ساخت ابزار از اجزای جداگانه، دیدگاه ما را درباره مهارتهای فنی آنها افزایش داده است. آویزهایی از جنس چنگال پرندگان و احتمالاً استفاده از پرها به عنوان زینت بدن نیز نمونههایی از نمادگرایی هستند، همراه حکاکیهای هندسی روی سنگ و استخوان.
نقاشان غار؟
برجستهترین ادعا اینست که نئاندرتالها با رنگدانههای قرمز روی دیوارههای غار در اسپانیا نقاشی کردند و هنر آفریدند. اما چندین مورد از ادعاهای مربوط به غارنگاره همچنان مشکلساز هستند. شواهد مربوط به غارنگارههای نئاندرتالها به دلیل مسائل روششناختی حلنشده تضعیف شده و بعید است درست باشند.
انباشت سریع شواهد برای حضور پیش از ۴۰۰۰۰ سال انسان مدرن در اروپا، این ایده را به چالش میکشد که نئاندرتالها این طرحهای هندسی را ساختهاند یا دستکم این کار را پیش از تأثیر انسانهای مدرن که از نمادها استفاده میکردند، انجام دادند. یک نیزهی چوبی هر قدر هم خوب ساخته شده باشد، چیزی بیش از یک چوب نوک تیز نیست و شواهد پیشرفت تکنولوژی در کل جامعۀ نئاندرتالها هنوز وجود ندارد.
در حالی که شواهد باستانشناسی مورد بحث باقی میماند، شواهد علوم اعصاب و ژنتیک مورد قانعکنندهای برای تفاوتهای زبانی و شناختی بین H. neanderthalensis و H. sapiens ارائه میکنند.

به نظر میرسد نئاندرتالها از پر به عنوان زینت بدن استفاده میکردند
به عنوان نمونه، یک بازسازی دیجیتالی سهبعدی از مغز نئاندرتال با تغییر شکل مغز H. sapiens و قرار دادن آن در قالب مغز (Endocast) از یک نئاندرتال، تفاوتهای قابلتوجهی در ساختار را نشان داد. نئاندرتالها لوب پس سری نسبتاً بزرگی داشتند، یعنی مواد مغزی بیشتر برای پردازش بصری و کمتر برای کارهای دیگری مانند زبان.
آنها دارای مخچهی نسبتاً کوچک و شکل متفاوتی نیز بودند. این ساختار زیر قشری مملو از نورون، به بسیاری از وظایف از جمله پردازش زبان، صحبت کردن و فصاحت کمک میکند.
برخی از جهشهای ژنتیکی مرتبط با آن رشد با رشد عصبی و نحوه اتصال نورونها در مغز مرتبط است. نویسندگان یک مطالعه جامع درباره تمام جهشهای شناختهشده منحصر به فرد انسان امروزی، به این نتیجه رسیدند که «تغییرات یک شبکه پیچیده در شناخت یا یادگیری در تکامل انسان مدرن اتفاق افتاده است».
کلمات نمادین
در حالی که چنین شواهدی در حال زیاد شدن است، درک ما از زبان نیز تغییر کرده است. سه پیشرفت دارای اهمیت خاصی هستند. نخست، کشف سال ۲۰۱۶ از طریق اسکن مغز که ما کلمات یا به بیان بهتر، مفاهیمی را که به کلمات ربط میدهیم، در هر دو نیمکره مغز و در خوشهها یا گروههای معنایی با مفاهیم مشابه در مغز ذخیره میکنیم. این کشف مهم است چون نحوه اتصال (یا عدماتصال) این دسته از ایدهها احتمالاً بین هومو ساپینسها و نئاندرتالها متفاوت است.
دوم، تشخیص این که اصوات نمادین (آنهایی که برداشت حسی از چیزی که نشان میدهند ایجاد میکنند) پل تکاملی بین صداهای جد مشترک ما در ۶ میلیون سال پیش و نخستین کلمات اداشده توسط هومو را ایجاد کردهاند.
واژگان نمادین امروزه در زبانها فراگیر هستند و جنبههایی از صدا، اندازه، حرکت و بافت مفهومی که کلمه نشان میدهد را به تصویر میکشند. این در تضاد با واژگانی است که فقط به دلخواه با چیزی که به آن اشاره میکنند مرتبط هستند. برای نمونه، یک سگسان را میتوان به همان اندازه به زبانهای مختلف dog، chien یا hund نامید، هیچ یک از آنها تصور حسی از حیوان ارائه نمیدهند.
سوم، مدلهای شبیهسازی رایانهای از انتقال زبان بین نسلها نشان دادهاند که دستور زبان (قوانین سازگار برای نحوه ترتیببندی کلمات برای تولید معنا) میتواند خود به خود پدیدار شود. این تغییر تأکید از رمزگذاری ژنتیکی دستور زبان به ظهور خود به خودی نشان میدهد زبان هومو ساپینس و نئاندرتال این قوانین را داشتند.
تفاوت کلیدی
در حالی که ممکن است بتوان به چندین روش مختلف قطعات پازل را کنار هم گذاشت، این شواهد چندرشتهای در نهایت تنها به یک راهحل ختم شده است. این راهحل با واژگان نمادینی آغاز میشود که گونه انسان باستانی هومو ارکتوس حدود ۱.۶ میلیون سال پیش ادا میکرد.
با انتقال این نوع واژگان از نسلی به نسل دیگر، واژگان و قواعد نحوی دلخواه پدید آمدند و ظرفیتهای زبانی و شناختی مشابهی را در اختیار نئاندرتالهای اولیه و هوموساپینسها قرار داد.
اما با ادامه تکامل هر دو گونه، اینها از هم جدا شدند. مغز هومو ساپینس شکل کروی خود را با شبکههای عصبی ایجاد کرد که خوشههای معنایی جداشده از واژگان را به هم متصل میکند. اینها در مغز نئاندرتالها جدا باقی ماندند. بنابراین، در حالی که هومو ساپینسها و نئاندرتالها ظرفیت مشابهی برای واژگان نمادین و نحو داشتند، به نظر میرسد از نظر ذخیره ایدهها در خوشههای معنایی در مغز متفاوت بودهاند.
گونه ما با پیوند دادن خوشههای مختلف در مغز که مسئول ذخیره گروهی از مفاهیم هستند، ظرفیت تفکر و برقراری ارتباط با استفاده از استعاره را به دست آورد. این تغییر به انسانهای مدرن اجازه داد بین مفاهیم و ایدههای بسیار متفاوت مرزبندی کنند.
شاید این مهمترین ابزار شناختی ما بود که ما را قادر ساخت مفاهیم پیچیده و انتزاعی پیدا کنیم. در حالی که واژگان و نحو نمادین بین هومو ساپینسها و نئاندرتالها مشترک بود، استعاره زبان، تفکر و فرهنگ گونه ما را دگرگون کرد و شکاف عمیقی بین ما و نئاندرتالها ایجاد کرد. آنها منقرض شدند، در حالی که ما جهان را پرجمعیت کردیم و به شکوفایی خود ادامه میدهیم.
مترجم: زهرا ذوالقدر